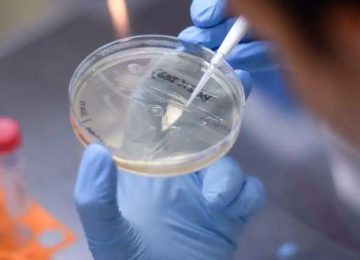
variante delta chile

Unión La Calera buscará este sábado ante Temuco avanzar a los octavos de final de la Copa Chile
Descargar artículo en formato PDF LA CALERA.- Este sábado26 de junio, a partir de las 18 horas, en el Estadio Municipal Nicolás Chahuán Nazar, Unión La Calera buscará clasificar a…
Leer más